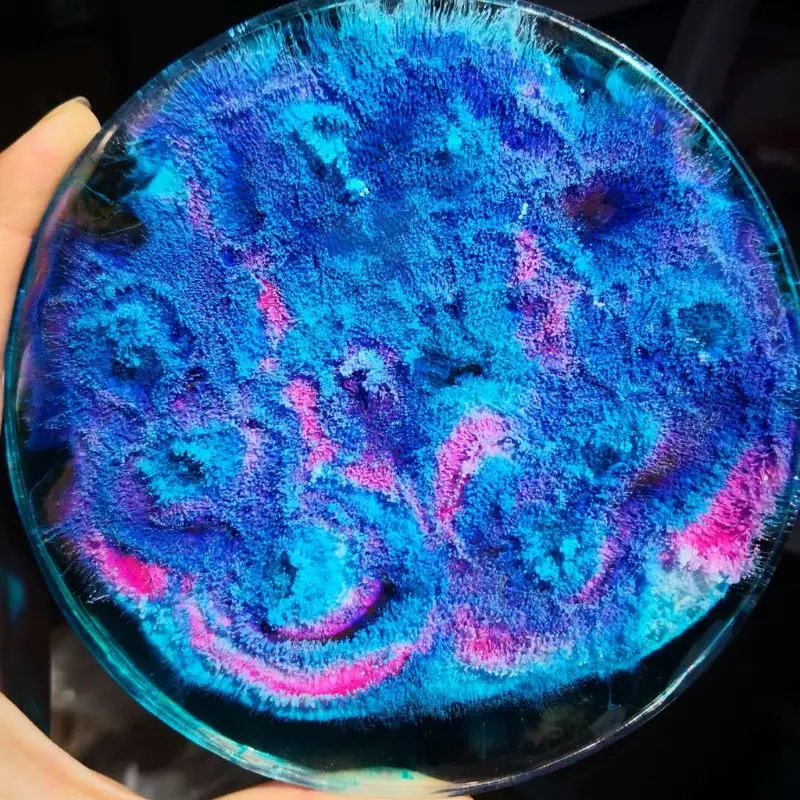
10ML Epoxy Resin Pigment Liquid Colorant Dye Ink Diffusion Resin Jewelry Making

Женское повседневное модное рождественское платье с V-образным вырезом в винтажном стиле XXXL
Графік зміни ціни & курс обміну валют
Користувачі також переглядали

461.51 руб.
Wrist Braces Softball Wristbands for Signs Leg Football Referee Accessories Arm Playbook Baseball Cards Youth
aliexpress.ru
535.35 руб.
Ветровые прядильщики KX4B для двора садовая металлическая ветряная мельница 3D Скульптуры ветра Спиннеры художественные для
aliexpress.ru
1,340.38 руб.
Переднее колесо Get Better Control с 10-дюймовым барабанным тормозом втулки переднего колеса и бескамерной шиной 60/70 65 для Ninebot Max G30
aliexpress.ru
4,399.17 руб.
Toner Chip Reset for HP Color LaserJet Enterprise M-555X M 554DN M 555DN M 555X M554-DN M555-DN M555-X M-554-DN M-555-DN M-555-X
aliexpress.com
3,188.82 руб.
Women Boots Autumn and winter New style Keep warm Cashmere Snow boots Rabbit's hair fashion Over the knee Chivalry boots 34-43
aliexpress.com
1,691.93 руб.
Наружная охотничья тропа, камера 12 МП, детектор диких животных, HD Водонепроницаемая инфракрасная камера с мониторингом
aliexpress.com
2,267.41 руб.
Car Sun Visor Beige Makeup Mirror Sun Shielding Board For Toyota Corolla 2001-2007 Left Driver and Right Passenger Side Sunvisor
aliexpress.com
3,025.08 руб.
LED Headlight HID Car Bulb LED 8000LM CSP Chip 6000K White 90W Easy Installation Plug And Play
aliexpress.com
1,587.59 руб.
Для Subaru Outback 2016-2020 Автомобильный Центральный экран управления навигацией Защита от царапин ТПУ Защитная пленка навигационная Мембрана пленка
aliexpress.com
12,398.11 руб.
100PCS For Micro SD SDHC TF to MS Memory Stick for Pro Duo Card Adapter Converter Memory Stick For PSP 1000 2000 3000
aliexpress.com
5,021.21 руб.
1Pcs For Samsung RAM 8GB 8G 2RX4 PC3L-12800R 1600 DDR3L Server Memory M393B1K70DH0-YK0
aliexpress.com
66,524.57 руб.
Оригинальный карданный модуль камеры PTZ компоненты камеры для DJI MAVIC AIR 2S Аксессуары для дрона запасные части
aliexpress.ru
7,014.92 руб.
100 шт./лот 9 размеров ПП пластиковый пакет с ручкой ПВХ Прозрачный матовый Подарочный пакет оптовая продажа с завода
aliexpress.ru
3,319.65 руб.
Sinolyn 2,5 дюйма Комплект биксеноновых прожекторов биксеноновые линзы для Фар H4, H7, 9005, 9006, линзы фары, ксеноновые линзы, лампы, фары, аксессуары д...
aliexpress.ru
5,616.75 руб.
Стоп светильник сигнал для багажника мотоцикла, сумки, колпачки, Спойлеры для Harley Touring Tour Pak Road Glide Road King 97-13 King, рубленая бритва
aliexpress.ru
4,494.69 руб.
8-дюймовая никелевая алюминиевая трубчатая внутренняя шарнирная рамка для кошелька
aliexpress.ru
96,314.70 руб.
200 шт. 80 мм прозрачный стеклянный исцеляющий хрустальный шар природная Волшебная Сфера реквизит для фотосъемки
aliexpress.ru
82,429.34 руб.
Мраморная Люстра для гостиной, Новая Европейская и американская хрустальная лампа
aliexpress.ru
1,446.54 руб.
WH Синий цвет, WH X12 работает подарок Оригинальная магнитная музыка Bluetooth-наушник
jd.ru
5,852.00 руб.
Мужские повседневные хлопковые льняные шорты с несколькими карманами, пляжные брюки для фитнеса и упражнений M светло-синий
joom.ru
993.65 руб.
Рулонный футляр для ручек, парусиновый органайзер для художественных работ, цветные кисточки, держатели для окрашивания, для студентов с др...
aliexpress.ru
309.01 руб.
10ML Epoxy Resin Pigment Liquid Colorant Dye Ink Diffusion Resin Jewelry Making
aliexpress.com
529.73 руб.
Outdoor Solar Human Body Induction Remote Control Wall Lamp LED Lighting Lamp With Adjustable Temperature Street Lamp
aliexpress.com
3,531.54 руб.
8M Wall Sconces Outdoor Lighting LED Wall Lamp Decorative For Bar KTV Project Patio Porch
aliexpress.com
208.68 руб.
Case For Huawei Honor 8 8X Max Note 10 Mate 20 10 9 V9 Lite Play Pro X Case G10 Car Magnet Honor 7X V10 V8 6C Pro Nova 2i Cover
aliexpress.com









